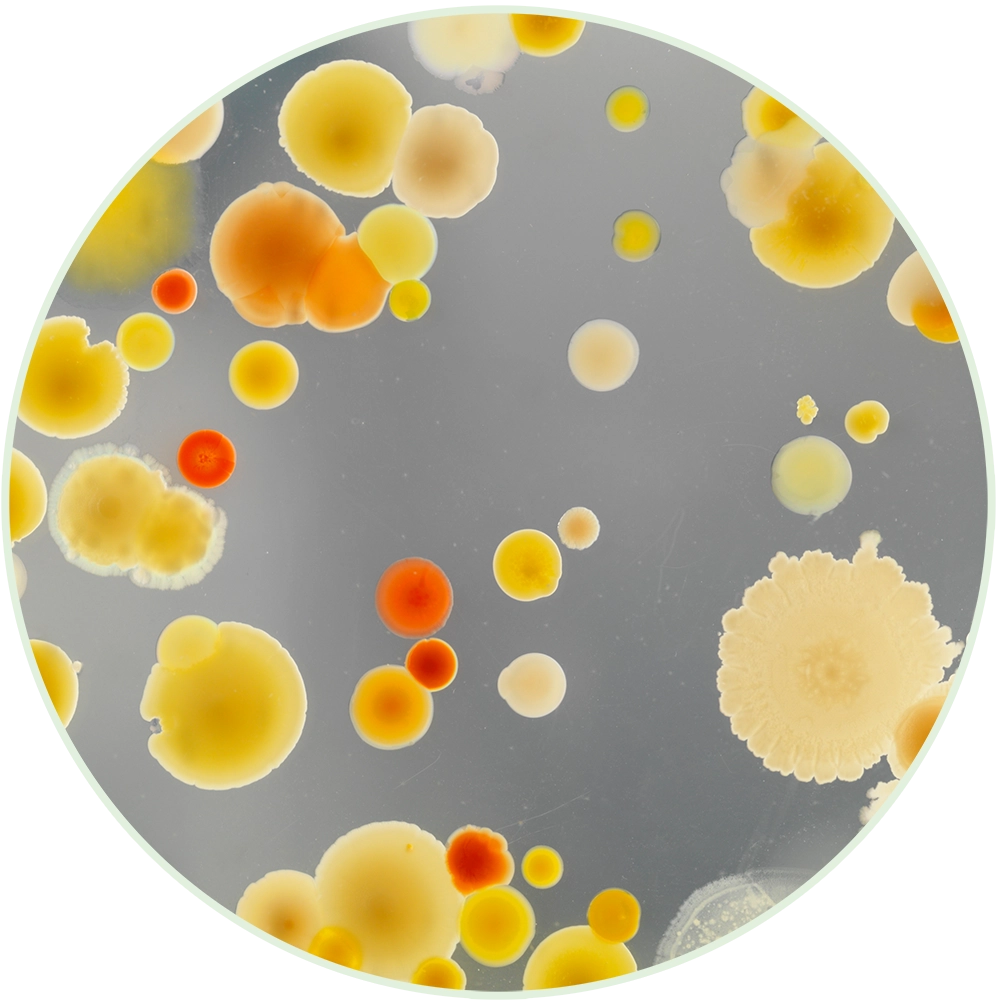
View through microscope

Roles of a
Medical Laboratory Technician and Medical Laboratory Scientist
Medical laboratory careers blend cutting-edge science with real-world impact. Medical Laboratory Technicians (MLT) and Medical Laboratory Scientists (MLS) generate test results that help unlock the mysteries of a patient’s health and influence most clinical decisions. This guide outlines clear steps to enter the medical laboratory profession from high school to employment, certification, and professional growth.

Step 1: High School Preparation
GOAL: Build a science and math foundation for college-level laboratory programs.
Recommended courses:
- Biology
- Chemistry
- Anatomy & Physiology
- Algebra and/or Statistics
- English Composition
Actions:
- Take the ACT and/or SAT
- Speak with your guidance counselor about:
- Dual credit opportunities
- Financial aid
- Local college partnerships
- Contact Human Resources departments at local hospitals and health care facilities to learn more about job shadow or observation opportunities and entry-level positions offered for high school students.

Resources:
- WhatsMyNext.org: Explore careers, find a school, talk to a career ambassador and learn from frequently asked questions
- LaboratoryScienceCareers.com: Learn more information on joining this profession.
Step 2: Enroll in an Accredited College Program
GOAL: Complete an accredited program
Health Care Student Scholarship Opportunities:
Click here for information

Lab Tech College Programs
Search for college programs in Lab Tech near you.
- Henderson Community College (Henderson)
- Jefferson Community and Technical College (Louisville)
- Madisonville Community College (Madisonville)
- Maysville Community and Technical College (Maysville)
- Somerset Community College (Somerset)
- Southcentral Kentucky Community and Technical College (Bowling Green)
- West Kentucky Community and Technical College (Paducah)
- American National University (Pikeville)

- University of Kentucky (Lexington)
- Traditional track
- MLT-to-MLS online path
- Eastern Kentucky University (Richmond)
- Owensboro Health Regional Hospital Medical Lab Science Program (Owensboro)
- St. Elizabeth School of Medical Lab Science (Edgewood)
Resources:
Step 3: Work in the Field
Check with your local hospital or health care facilities for opportunities:
- Shadow or volunteer
- Entry-level positions for high school students
- Summer health care camps for students
College
Entry-Level hospital roles may include, but are not limited to:
- Food Services
- Environmental Services
- Patient Transport
- Nursing Assistant
- Phlebotomy – certificate program
- Medical Laboratory Assistant – certificate program
Hospital Career Search
Visit the Kentucky Hospital Job Center
Search for current positions open at Kentucky hospitals, leading to exceptional careers
Step 4: Obtain National Certification
The most common certification required is through the American Society for Clinical Pathology (ASCP) Board of Certification (BOC). Some employers may also accept certification through American Medical Technologists (AMT).
- Verify exam eligibility requirements
- Explore Specialist certification exams
- Find ASCP eligibility details, an exam application, and continuing education requirements: https://www.ascp.org
- Find AMT eligibility details, an exam application, and continuing education requirements: https://americanmedtech.org

Step 5: Understand Kentucky Regulations
Kentucky does not license individual laboratory professionals; however, clinical laboratories must be licensed by the state and meet personnel standards.

Step 6: Pursue Professional Growth & Continuing Education
GOAL: Continue learning and stay involved in your field.
- The American Society for Clinical Laboratory Science (ASCLS)
- National advocacy, continuing education and networking
- The Kentucky Society for Clinical Laboratory Science (KSCLS)
- State advocacy, continuing education and networking
- American Society for Clinical Pathology (ASCP)
- Networking, education, and scholarships
- All laboratory students are eligible for free membership while in school

- Pursue specialist certifications, which include, but are not limited to:
- Specialist in Blood Banking (SBB)
- Specialist in Chemistry (SC)
- Specialist in Microbiology (SM)
- Leadership roles
- Lead MLT or MLS, supervisor, manager, or director
- MLT-to-MLS completion programs enable upward mobility while working.

Pathway to a Career
Medical Laboratory Technician
and Medical Laboratory Scientist
Step 1: High School Preparation
Take college preparatory courses
Take the ACT and/or SAT
Speak with your guidance counselor
Contact HR at hospitals to job shadow

Step 2: Enroll in an Accredited College Program
Obtain an Associate Degree for Medical Laboratory Technician (MLT) or Bachelor’s Degree for Medical Laboratory Scientist (MLS)

Step 3: Begin Working in the Field

Lab-Specific Roles – Generally, on-the-job training is provided, but some employers may prefer or require formal training and certification
- Phlebotomist
- Laboratory Aide
- Medical Laboratory Assistant
- Laboratory Assistant

Entry Level Roles – Generally, on-the-job training is provided
Examples include:
- Food Services
- Patient Transport
- Environmental Services
- Nursing Assistant

Step 4: Pass National Certification (Generally required by employers)

Step 5: Start Career as a Laboratory Professional
- Complete an accredited college degree program
- Obtain national certification

Roles after College and Certification
- Medical Lab Technician (MLT) – Associate Degree
- Medical Lab Scientist (MLS) – Bachelor’s Degree

Advanced Roles May Include:
- Specialist certifications
- Specialist in Blood Banking (SBB)
- Specialist in Chemistry (SC)
- Specialist in Microbiology (SM)
- Leadership Roles
- Lead Tech or Scientist
- Supervisor
- Manager
- Director

Step 6: Professional Growth & Engagement
- Maintain continuing education (CE) credits
- Get involved in professional organizations
- The American Society for Clinical Laboratory Science (ASCLS)
- The Kentucky Society for Clinical Laboratory Science (KSCLS)
- American Society for Clinical Pathology (ASCP)


